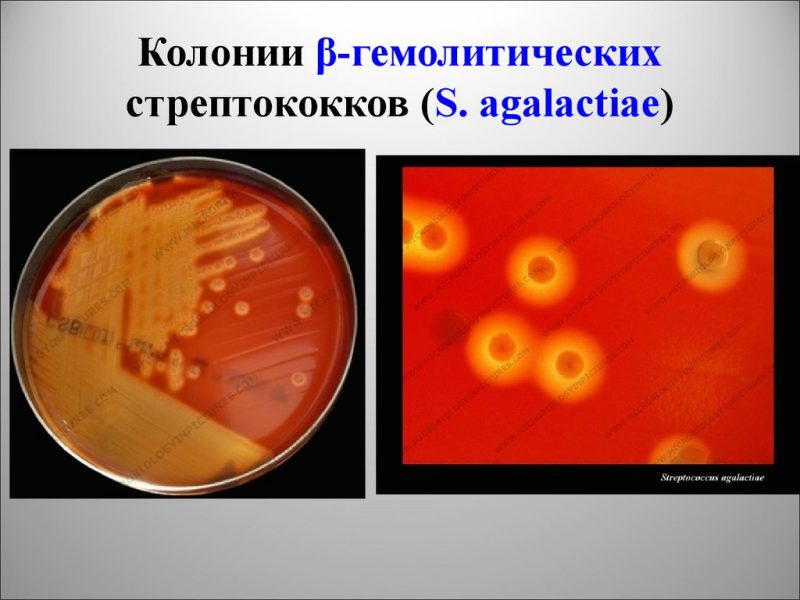
Стрептококк агалактия виды

Стрептококки агалактия (streptococcus agalactiae) – микроорганизмы семейства Стрептококковые. Они являются условно-патогенной разновидностью бактерий. Микроорганизмы в небольшом объеме могут существовать в теле человека, не угрожая при этом здоровью. Бактерии обитают в органах мочевыделительной и половой систем. Стрептококки агалактия имеют форму шара или овала.
Проникая в организм, размещаются парно, в виде цепочки. При нарушении нормального баланса микрофлоры концентрация стрептококков агалактия начинает стремительно увеличиваться, провоцируя острые воспалительные процессы.
Разновидности
Существует более 40 видов стрептококков.
Их объединяют в 4 основные группы:
Стрептококк агалактия принадлежит к группе бета-гемолитических стрептококков. Впервые он был обнаружен у коров, больных маститом.
Стрептококк агалактия, обнаруживаемый в мазке или моче, вызывает у врачей серьезные опасения. Этот микроорганизм, традиционно ассоциируемый с инфекциями у новорожденных, может также проявляться у взрослых, что требует внимательного подхода к диагностике и лечению. Врачи отмечают, что у мужчин и женщин симптомы могут варьироваться, включая дискомфорт, воспаление и даже более серьезные осложнения, если инфекция не будет своевременно выявлена. Специалисты подчеркивают важность регулярных обследований, особенно для групп риска, таких как беременные женщины. Лечение обычно включает антибиотики, однако выбор препарата зависит от чувствительности штамма. Врачи настоятельно рекомендуют не игнорировать симптомы и обращаться за медицинской помощью при первых признаках инфекции.
https://youtube.com/watch?v=0qpMp5I-qUs
Способы заражения
Микроорганизм обитает преимущественно в урогенитальном тракте, прямой кишке и верхнем отделе глотки. Инфицирование происходит чаще всего половым путем. Другими способами заражения являются:
У мужчин заражение streptococcus agalactiae происходит при незащищенном сексе или снижении защитных сил организма.
У женщин активация патогенных микроорганизмов наблюдается при:
Причиной роста и размножения стрептококков агалактия у представителей обоих полов может быть также сахарный диабет.
Заражение новорожденного

Инфицирование происходит чаще всего во время прохождения по родовым путям, реже – при контакте с матерью или персоналом роддома.
Предрасполагающими к развитию стрептококковой инфекции у грудного ребенка являются определенные факторы:
Иногда заражение происходит внутриутробно.
Инфицирование возможно при выполнении диагностических и лечебных манипуляций:
Заражение стрептококком агалактия в подобных случаях – результат несоблюдения правил асептики.
Стрептококк агалактия, или Streptococcus agalactiae, часто вызывает вопросы и беспокойство у пациентов, когда обнаруживается в мазке или моче. У женщин этот микроорганизм может быть ассоциирован с инфекциями мочевыводящих путей и вагинальными инфекциями, что вызывает дискомфорт и необходимость в лечении. Мужчины, в свою очередь, могут столкнуться с менее распространенными, но все же серьезными последствиями, такими как простатит. Многие пациенты отмечают, что информация о стрептококке агалактия часто недостаточно освещена, и это приводит к страху и недопониманию. Важно помнить, что наличие этого микроорганизма не всегда означает наличие заболевания; иногда он может быть частью нормальной микрофлоры. Консультация с врачом и проведение дополнительных исследований помогут прояснить ситуацию и определить необходимость лечения.
https://youtube.com/watch?v=lS-kjxnwLMY
Признаки
При увеличении количества условно-патогенных бактерий в женском организме, развивается определенная симптоматика.
Основными проявлениями воспалительного процесса становятся:

Чрезмерная концентрация streptococcus agalactiae в мазке у женщин (более чем 10*5 КОЕ/мл) обычно указывает на цистит или вульвовагинит.
Патологический процесс, спровоцированный стрептококками агалактия, у мужчин вызывает чаще всего воспаление мочеиспускательного канала и мочевого пузыря.
Основные проявления:
У мужчин может наблюдаться также небольшое воспаление и выделения с гнойным содержимым из полового члена.
Стрептококк агалактия при беременности
В период вынашивания ребенка происходит перестройка гормонального фона женщины. Увеличивается концентрация прогестерона, снижается иммунитет. В результате возможно обострение различных инфекций органов мочеполовой системы.
В группе повышенного риска по развитию патологического состояния находятся:
Частым осложнением воспалительного процесса, спровоцированного условно-патогенными бактериями, является послеродовой эндометрит.
Обследование беременных с повышенным риском развития инфекции или уже имеющих ее включает:
Диагностика выполняется на последнем месяце беременности. К этому сроку концентрация бактерий достигает наибольшего количества.
Обследования

Диагностирование воспалительного процесса у мужчин и женщин объединяет лабораторные и инструментальные способы.
Главные исследования:
Комплексное обследование помогает специалисту определить диагноз и подобрать адекватное лечение.
Терапия
Лечение стрептококка агалактия выполняется антибиотиками. Курс терапии продолжается не менее 5 дней.
Эффективными препаратами являются:
При аллергии на антибиотики назначаются макролиды (Эритромицин, Азитромицин, Джозамицин).
Женщинам может быть рекомендован Гексикон. Это вагинальные свечи, оказывающие антисептическое и дезинфицирующее действие.
В некоторых случаях терапия дополняется стрептококковыми бактериофагами.
Для нормализации работы ЖКТ назначаются пробиотики (Линекс, Бифидумабактерин, Ацилакт, Аципол).
Сорбенты (Атоксил, Полисорб, Альбумин, Смекта) способствуют качественному выведению токсинов.

Применение иммуностимуляторов (Лизобакт, Имунорикс, Имудон) позволяет улучшить состояние иммунитета и усилить действие антибиотиков.
При возникновении аллергических реакций назначаются антигистаминные препараты (Цетрин, Кларитин).
Лечение при беременности
Если существует опасность инфицирования ребенка при родах, то терапия антибактериальными препаратами выполняется непосредственно в процессе родоразрешения, а также после разрыва околоплодного пузыря и отхождения амниотической жидкости. Более раннее лечение не будет достаточно эффективным, патогенные микроорганизмы продолжат размножение. Для санации влагалища могут быть назначены вагинальные таблетки и свечи (Флуомизин, Тержинан, Гексикон).
Лечение стрептококка агалактии проводится под контролем врача. Все рекомендации должны выполняться. Санация влагалища или терапия антибиотиками помогают уменьшить риск заражения ребенка.

Возможные осложнения
Размножение условно-патогенных бактерий приводит к выделению токсических веществ, которые с током крови разносятся во все системы и органы.
Они воздействуют на защитные способности организма, вызывая аутоиммунные заболевания:
У беременных, имеющих высокий титр концентрации стрептококков агалактия в мазке или моче, при отсутствии своевременной терапии могут возникнуть серьезные осложнения.
Чаще всего развивается:
У грудного ребенка заражение стрептококком агалактия может вызвать не менее тяжелые последствия.
Возможно:
Летальный исход отмечается более чем в половине случаев заражения новорожденных.
Народные средства

Естественный иммуностимулятор – аскорбиновая кислота (витамин С). Полезного вещества много в шиповнике, клюкве, лимоне, облепихе, смородине, калине.
Популярными рецептами для лечения стрептококка агалактия являются:
Важно включить в ежедневный рацион лук и чеснок. Эти растения являются природными антибиотиками и антиоксидантами, источниками комплекса витаминов. Свежие абрикосы, принимаемые внутрь при стрептококковой инфекции, также эффективно уничтожают условно-патогенные бактерии.
Профилактика

Выполнение профилактических мероприятий помогает снизить вероятность заражения стрептококком агалактия.
Основными рекомендациями являются:
Активизация стрептококка агалактии – серьезная опасность для здоровья. Микроорганизмы, размножаясь, провоцируют распад эритроцитов. Своевременная диагностика и терапия помогают избежать развития различных осложнений.
https://youtube.com/watch?v=ZhHYJMFYuHM
Вопрос-ответ
Могут ли мужчины заразиться стрептококком агалактии группы В?
Стрептококк группы B, как правило, безвреден, и большинство людей даже не подозревают о его наличии.
Какова норма Streptococcus Agalactiae у мужчин?
Результаты исследований обычно описывают как «отсутствует» или «присутствует» бактерия в мочеполовой системе человека в зависимости от роста колонии на питательной среде. При этом, при бессимптомном носительстве нормой Streptococcus agalactiae у мужчин может считаться количество бактерий меньше 10^4 КОЕ/мл.
Нужно ли лечить стрептококк в мазке у женщин?
Без лечения стрептококковая инфекция может увеличивать риск: преждевременных родов, внутриутробного поражения плода. Женщина во время родов может передать стрептококк своему ребенку. Носительницами стрептококка группы B являются примерно 25% беременных женщин.
Что такое Streptococcus agalactiae в мужской моче?
Streptococcus agalactiae (стрептококк группы B, или СГБ) часто вызывает различные инфекции мочевыводящих путей (ИМП), включая бессимптомную бактериурию, цистит, пиелонефрит, уретрит и уросепсис. Хотя заболеваемость новорожденных, вызванная СГБ, снизилась, её распространённость среди небеременных взрослых возросла.
Советы
СОВЕТ №1
Обязательно проконсультируйтесь с врачом при обнаружении стрептококка агалактия в анализах. Самолечение может привести к осложнениям, поэтому важно получить профессиональную медицинскую помощь и назначение соответствующего лечения.
СОВЕТ №2
Следите за своим иммунитетом. Укрепление иммунной системы с помощью правильного питания, физической активности и достаточного сна может помочь организму справиться с инфекциями, включая стрептококковые.
СОВЕТ №3
Регулярно проходите медицинские обследования, особенно если у вас есть предрасположенность к инфекциям. Это поможет выявить проблемы на ранних стадиях и предотвратить развитие серьезных заболеваний.
СОВЕТ №4
Обратите внимание на личную гигиену и соблюдение правил безопасности, особенно в общественных местах. Это поможет снизить риск заражения и распространения инфекций, включая стрептококки.










